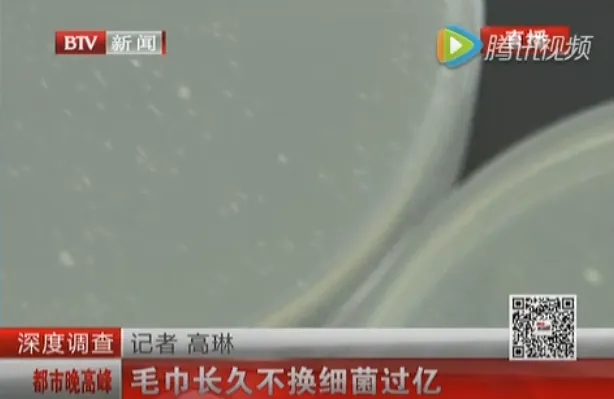

建议大家:卫生间不要再放这3样物品了,是为你好,别不当回事!

文章图片

文章图片

文章图片

文章图片

文章图片

文章图片

文章图片

文章图片

文章图片

文章图片

文章图片

文章图片
文章图片

文章图片
卫生间是家里边非常重要的一个区域 ,
因为这个地方不仅仅要用来如厕 , 还要淋浴 ,
日常洗漱以及一些家居清洁物品 , 都要放在这个区域 。
如果卫生间不好好清洁的话 , 就会容易滋生细菌 , 散发异味 ,
我之前就去过不少朋友家 ,
每次进入卫生间都会觉得十分拥挤 , 而且还会有一股异味 。
下面就来跟大家分享一下 , 不管你家卫生间有多大 ,
这3样东西尽量都不要放 , 其中大有讲究 , 是为你好 , 千万不要不当回事 。
1、马桶刷
相信很多人在看到马桶刷以后都会产生疑问 ,
卫生间不放置马桶刷 , 应该怎么清洁马桶呢?
不过大家将马桶刷放在卫生间 ,
其实主要就是为了解决细菌滋生和异味的问题 ,
很多人都不知道为什么家里面卫生间全是臭味 ,
只顾着清洁马桶 , 忘了清洁马桶刷 。
马桶刷每次在清洁完马桶以后 , 上面肯定会残留大量的污垢 ,
如果这些污垢不清洁干净的话 , 肯定就会滋生细菌 ,
甚至还会产生异味放置在卫生间的角落 , 这不就是细菌的培养皿吗?
推荐给大家2款可以代替马桶刷的好物 , 大家有需要的可以种草一下 。
①马桶清洁魔瓶
这种清洁好物简直就是专门为懒人而准备的 ,
因为只需要将其放进马桶水箱里 ,
它就会源源不断地释放出大量的清洁因子和植物精粹 。
这样在我们每次冲水的时候都相当于清洁一次马桶 ,
而且它不仅可以溶解污垢 , 还可以消毒抑菌、除异味 。
- 开荒保洁收费标准 开荒保洁哪里好
- lol千珏背景故事 lol千钰叫什么
- 卧室最好不要摆放这些东西——明镜阁王师傅建议
- 宽带钻教程 宽带钻是什么意思
- 你们过年回家都给爸妈买什么礼物呀,给个建议铁子们?
- 诺贝利是什么
- 汽车f1是什么意思 F1是什么楼层
- 国内a股交易时间 中国A股交易时间
- lol英雄末日使者出装 末日使者 出装
- 甲醛可默默潜藏15年,这“3招”除醛省钱且有效,建议各位试试
特别声明:本站内容均来自网友提供或互联网,仅供参考,请勿用于商业和其他非法用途。如果侵犯了您的权益请与我们联系,我们将在24小时内删除。
